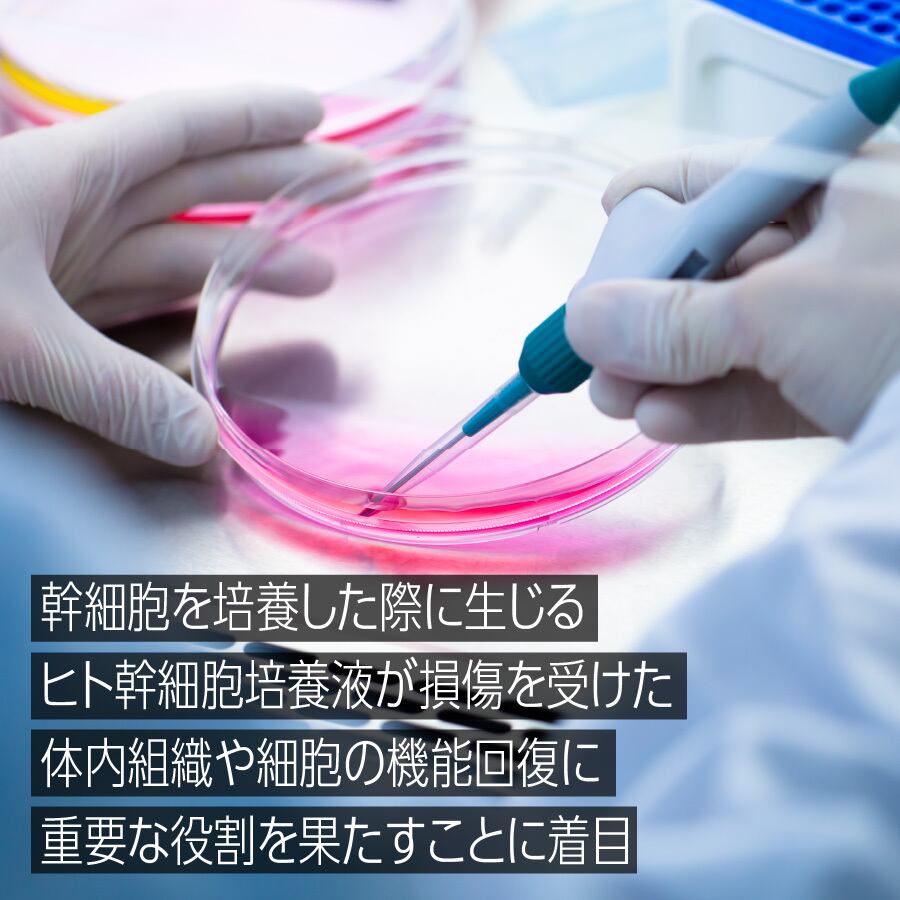

リフォルメ RC ロイヤルマスク
¥1,650
男女兼用 1枚入り
内容量23mL
1,650円〈税込〉
闘うアスリートの肌を守り抜く、ヒト幹細胞培養液*「集中リカバリーマスク」
*ヒト脂肪細胞順化培養液(保湿成分)
●紫外線や大気汚染物などで肌にとって苛酷な環境でプレイした後は一刻も早いレスキューケアが必要。
●「リフォルメ RC ロイヤルマスク」は、アウトドアでアクティブに活動するアスリートのためにつくられたフェイスマスク。
●米国や韓国で注目される話題の「ヒト幹細胞培養液」をキー成分に、厳選された10種の美容成分を贅沢に配合。乾燥、くすみ**、ハリ・ツヤ不足といった肌悩みに多角的にアプローチし、ダメージ肌を集中メンテナンスします。
**乾燥による
<全成分>
水、BG、グリセリン、ヒト脂肪細胞順化培養液、プラセンタエキス、3-0-エチルアスコルビン酸、加水分解エラスチン、水溶性プロテオグリカン、オリゴペプチド-24、α-アルブチン、加水分解コラーゲン、β-グルカン、セレブロシド、ヒアルロン酸Na、PEG-60水添ヒマシ油、キサンタンガム、カプリロイルグリシン、グリチルリチン酸2K、EDTA-2Na、クエン酸、クエン酸Na、リン酸、フェノキシエタノール、メチルパラベン
強い日差しを浴びた日は一刻も早いレスキューケアを

紫外線でダメージを受けた肌は、火傷しているも同然。年齢を重ねるほどにダメージは蓄積されやすくなるので、時間差でシミやシワ、たるみといったトラブルが発生することもあります。ダメージを受けた肌に必要なのは、一刻も早いリペアなのです。
「ヒト幹細胞培養液」は、美容医療の現場でも常に注目を集めている成分のひとつ。肌の再生を助けるような働きがあり、さまざまな肌トラブルをトータルでケアすることが期待できます。野外でアクティブに活動する方にこそ、知っておいてほしい成分です。
<Doctor's profile>
医療法人社団 白鳳会 ピュア形成外科医院
井上 普文
http://www.i-clinic.org/
医学博士 日本形成外科学会認定専門医
日本美容外科学会正会員
日本アンチエイジング医療協会 会員
西日本皮膚科学会員
苛酷な環境にさらされやすいアスリートのためにようやく見つけた特別な成分「ヒト幹細胞培養液」
Re:formeを立ち上げたのは、現役のアスリート。紫外線や大気汚染物など苛酷な環境で活躍するアスリートが、スポーツをめいっぱい楽しむことはできないのだろうか。アスリートの肌ダメージをケアするアイテムを作れないだろうか。そう考えていたときに辿り着いたのが「ヒト幹細胞培養液」でした。
ヒントになったのは、世界で活躍する著名なアスリートが、自身のメンテナンスに幹細胞治療を取り入れていたこと。調査をするうちに、ヒトの幹細胞を培養した際に生じるヒト幹細胞培養液も、損傷を受けた体内組織や細胞の機能回復に重要な役割を果たすことがわかりました。そうしてヒト幹細胞培養液をキー成分に、日々太陽の下で闘うアスリートや、野外でアクティブに活動する人たちのためのスキンケアアイテムを作ることにしたのです。
<ヒト幹細胞培養液とは>
幹細胞を培養した際に、幹細胞が産生したさまざまなタンパク質を含む分泌液のことであり、幹細胞そのものが入っているわけではありません。グロスファクター(細胞増殖促進因子)やサイトカイン(生理活性物質)といった500種類以上のたんぱく質を含んでおり、米国や韓国では、うるおい、ハリ・弾力、くすみなど、さまざまなトラブルにアプローチすることが期待できる成分として、すでに認知されています。
リフォルメ RC ロイヤルマスク5つのこだわり
❶安心安全を届ける純国産のヒト幹細胞培養液
❷厳選された10種の美容成分がダメージ肌に多角的にアプローチ
❸約1か月分の美容成分が今日のダメージを「なかった」ことに
❹特別なシートが、傷んだ肌にやさしくピタっと密着
➎7つの「刺激フリー」で誰でも使いやすく
※すべての方にアレルギーや肌トラブル、皮膚刺激が起こらないということではありません
効果の上がるマスクの使い方
❶しっかりと洗顔した後のまっさらな状態の肌に、シートを乗せます。
❷隙間ができないようにシートをぴったりと貼りつけ、そのまま15分ほど密着させます。
❸シートをはがします。肌表面に残った美容液を、手のひらで摩擦しないようにゆっくりと肌に押し込みます。
❹さらに残った美容液を、首やデコルテ、うなじまで伸ばし、やさしくなじませたら、乳液などで保湿してください。
<使用上の注意>
●お肌に異常があるときは使用しないでください。●お肌に合わないとき、すなわち次のような場合には、ご使用を中止してください。そのまま使用を続けますと、症状を悪化させることがありますので、皮膚科専門医などにご相談されることをおすすめします。①使用中、赤み、はれ、かゆみ、刺激、色抜け(白斑など)や黒ずみなどの異常が現れた場合。②使用したお肌に、直射日光が当たって上記のような異常が現れた場合。●お肌に異常が生じていないかよく注意してご使用ください。●目に入らないように注意してください。もし目に入った場合は、すぐに洗い流してください。●幼児への使用、または手の届くところには置かないでください。●保管は直射日光を避けて常温で保管してください。●開封後は速やかにご使用ください。●一度使用したマスクはお使いにならないでください。